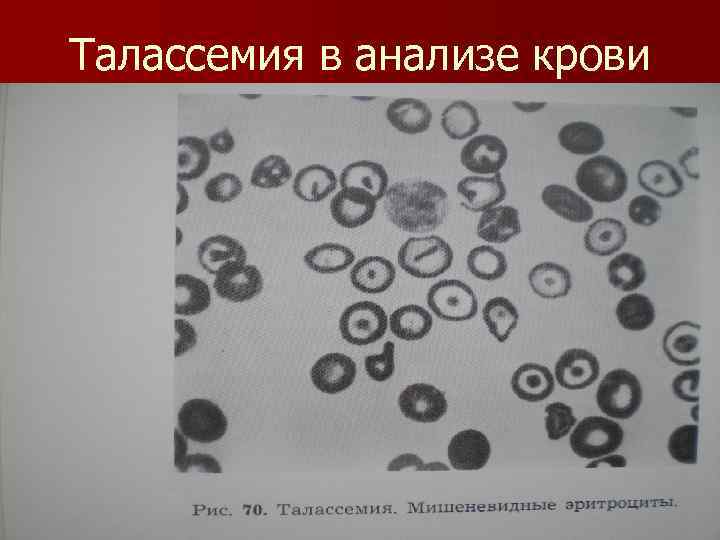
Талассемия в анализе крови

анемии (5).ppt
- Количество слайдов: 34
 Дифференциальная диагностика и лечение анемий. Вопросы дифференцированной терапии гемотрансфузиологии Мультимедийный атлас к практическим занятиям по гематологии, VI курс
Дифференциальная диагностика и лечение анемий. Вопросы дифференцированной терапии гемотрансфузиологии Мультимедийный атлас к практическим занятиям по гематологии, VI курс
 Кроветворение при постгеморрагической анемии
Кроветворение при постгеморрагической анемии
 Картина крови при хронической постгеморрагической анемии
Картина крови при хронической постгеморрагической анемии
 Картина крови при перницитозной анемии(тяжелое течение)
Картина крови при перницитозной анемии(тяжелое течение)
 Картина крови при перницитозной анемии в стадии ремиссии
Картина крови при перницитозной анемии в стадии ремиссии






 Костный мозг при гипопластической анемии
Костный мозг при гипопластической анемии
 Схема резус-несовместимости при гемолитической болезни новорожденных
Схема резус-несовместимости при гемолитической болезни новорожденных
 Патогенез серповидно клеточной анемии
Патогенез серповидно клеточной анемии
 Дактилит при серповидноклеточной анемии
Дактилит при серповидноклеточной анемии
 Кровь при серповидноклеточной анемии
Кровь при серповидноклеточной анемии

 Талассемия
Талассемия
Талассемия в анализе крови
Талассемия в анализе крови
 Анемия n Называют состояние, характеризующееся уменьшением количества эритроцитов и (или) снижением содержания гемоглобина в единице объема крови.
Анемия n Называют состояние, характеризующееся уменьшением количества эритроцитов и (или) снижением содержания гемоглобина в единице объема крови.
 Классификация n. В зависимости от показателей гематокрита различают: n Простую n Полицитемическую n Нормохромную n Гиперхромную
Классификация n. В зависимости от показателей гематокрита различают: n Простую n Полицитемическую n Нормохромную n Гиперхромную
 Классификация I. Анемии из-за кровопотерь 1. Острая постгеморрагическая (нормохромная) 2. Хроническая постгеморрагическая (гипохромная) II. Анемии из-за нарушения кровообразования 1. Железодефицитные анемии: ГИПОХРОМНЫЕ АНЕМИИ: n
Классификация I. Анемии из-за кровопотерь 1. Острая постгеморрагическая (нормохромная) 2. Хроническая постгеморрагическая (гипохромная) II. Анемии из-за нарушения кровообразования 1. Железодефицитные анемии: ГИПОХРОМНЫЕ АНЕМИИ: n
 А. Нутритивные железодефицитные анемии детского возраста Б. Анемии из-за эндогенной недостаточности железа, из-за высоких запросов организма в период роста, беременности, лактации. а) ювинильный хлороз б) ЖДА беременных и кормящих В. Анемии из-за резорбционной недостаточности железа (при патологиях ЖКТ): а)ахлоргидридная ЖДА б) агастритическая (после резекции желудка)
А. Нутритивные железодефицитные анемии детского возраста Б. Анемии из-за эндогенной недостаточности железа, из-за высоких запросов организма в период роста, беременности, лактации. а) ювинильный хлороз б) ЖДА беременных и кормящих В. Анемии из-за резорбционной недостаточности железа (при патологиях ЖКТ): а)ахлоргидридная ЖДА б) агастритическая (после резекции желудка)
 в) анэнтеральная ЖДА (после резекции кишечника) 2. Железонасыщенные сидерохристические анемии: А. Наследственные Б. Приобретенные 3. В 12 фолево-дефицитные анемии (экзогенная недостаточность витамина В 12): МЕГОБЛАСТНЫЕ ГИПЕРХРОМНЫЕ АНЕМИИ: А. Нутритивная Б. Радиационная (при лучевой болезни) В. Медикаментозная (фенобарбиталовая)
в) анэнтеральная ЖДА (после резекции кишечника) 2. Железонасыщенные сидерохристические анемии: А. Наследственные Б. Приобретенные 3. В 12 фолево-дефицитные анемии (экзогенная недостаточность витамина В 12): МЕГОБЛАСТНЫЕ ГИПЕРХРОМНЫЕ АНЕМИИ: А. Нутритивная Б. Радиационная (при лучевой болезни) В. Медикаментозная (фенобарбиталовая)
 4. Эндогенная недостаточность витамина В 12 n 1). Нарушенная ассимиляция пищевого витамина В 12 из-за выпадения секреции желудочного мукопротеина: А. Пернициозная анемия Б. Симптоматическая анемия пернициозного типа при раке, сифилисе, полипозе желудка, ожогах, азотемии В. Агастральная анемия перницитозного типа при гастроэктомии, резекциях желудка.
4. Эндогенная недостаточность витамина В 12 n 1). Нарушенная ассимиляция пищевого витамина В 12 из-за выпадения секреции желудочного мукопротеина: А. Пернициозная анемия Б. Симптоматическая анемия пернициозного типа при раке, сифилисе, полипозе желудка, ожогах, азотемии В. Агастральная анемия перницитозного типа при гастроэктомии, резекциях желудка.
 2). Нарушенная ассимиляция витамина В 12 в кишечнике А. Глистная пернациозная анемия Б. Фолево-дефицитная спру анемия В. Анентеральная фолеводефицитная анемия из-за резекции тонкой кишки, дивертикула слепой кишки.
2). Нарушенная ассимиляция витамина В 12 в кишечнике А. Глистная пернациозная анемия Б. Фолево-дефицитная спру анемия В. Анентеральная фолеводефицитная анемия из-за резекции тонкой кишки, дивертикула слепой кишки.
 3). Повышенное расходование витамина В 12 А. Злокачественное малокровие беременных Б. Симптоматические макроцитарные фолиеводефицитные анемии при циррозах печени
3). Повышенное расходование витамина В 12 А. Злокачественное малокровие беременных Б. Симптоматические макроцитарные фолиеводефицитные анемии при циррозах печени
 5. В 12 -ахрестические анемии А. Гипнрхромная мегобластная анемия из-за нарушенной ассимиляции витамина В 12 костным мозгом при эритромиелозе.
5. В 12 -ахрестические анемии А. Гипнрхромная мегобластная анемия из-за нарушенной ассимиляции витамина В 12 костным мозгом при эритромиелозе.
 6. Гипо-апластические анемии А. Из-за воздействия экзогенных факторов: а) физических б) химических в) медикаментозных г) антибиотиков Б. Из-за эндогенной аплазии костного мозга: а) семейная апластическая анемия б) детская апластическая анемия в) апластическая анемия г) остеопетрозная анемия (мраморная болезнь)
6. Гипо-апластические анемии А. Из-за воздействия экзогенных факторов: а) физических б) химических в) медикаментозных г) антибиотиков Б. Из-за эндогенной аплазии костного мозга: а) семейная апластическая анемия б) детская апластическая анемия в) апластическая анемия г) остеопетрозная анемия (мраморная болезнь)
 7. Метапластические анемии А. При лейкозах Б. При миеломатозе В. При метастазах рака в костном мозге
7. Метапластические анемии А. При лейкозах Б. При миеломатозе В. При метастазах рака в костном мозге
 III. Гемолитические анемии 1. Анемии обусловленные экзоэритроцитарными гемолитическими факторами А. Токсические а) при отравлении ядами б) при тяжелых ожогах Б. Инфекционные (малярия, сепсис и т. д. ) В. Посттрансфузионные: а)из-за переливания несовместимой крови б) из-за переливания резуснесовместимой крови n
III. Гемолитические анемии 1. Анемии обусловленные экзоэритроцитарными гемолитическими факторами А. Токсические а) при отравлении ядами б) при тяжелых ожогах Б. Инфекционные (малярия, сепсис и т. д. ) В. Посттрансфузионные: а)из-за переливания несовместимой крови б) из-за переливания резуснесовместимой крови n
 Г. Иммуные а) эритробластоз плода и новорожденных б) аутоиммунные Д. Пароксизмальная гемоглобинурия
Г. Иммуные а) эритробластоз плода и новорожденных б) аутоиммунные Д. Пароксизмальная гемоглобинурия
 2. Анемии обусловленные эндоэритроцитарными факторами А. Эритроцитопатии а) врожденные • Микросфероцитарная • Овалоцитарная б) Приобретенная хроническая
2. Анемии обусловленные эндоэритроцитарными факторами А. Эритроцитопатии а) врожденные • Микросфероцитарная • Овалоцитарная б) Приобретенная хроническая
 Б. Энзимопении а) Дефицит глюкозо 6 -фосфатдегидрогеназы б)Дефицит пируваткиназы в) Дефицит глютатион-редуктазы В. Гемоглобинопатии а) Талассемия • Большая • Малая • Минимальная б)Серповидноклеточная анемия
Б. Энзимопении а) Дефицит глюкозо 6 -фосфатдегидрогеназы б)Дефицит пируваткиназы в) Дефицит глютатион-редуктазы В. Гемоглобинопатии а) Талассемия • Большая • Малая • Минимальная б)Серповидноклеточная анемия


